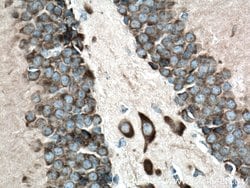
FARSB Rabbit anti-Human, Mouse, Rat, Polyclonal, Proteintech 150 &mu;L;

missing translation for 'onlineSavingsMsg'
Learn More
Learn More
FARSB Rabbit anti-Human, Mouse, Rat, Polyclonal, Proteintech
Rabbit Polyclonal Antibody
Brand: Proteintech 16341-1-AP-150UL
This item is not returnable.
View return policy
Description
This gene encodes a highly conserved enzyme that belongs to the aminoacyl-tRNA synthetase class IIc subfamily. This enzyme comprises the regulatory beta subunits that form a tetramer with two catalytic alpha subunits. In the presence of ATP, this tetramer is responsible for attaching L-phenylalanine to the terminal adenosine of the appropriate tRNA. A pseudogene located on chromosome 10 has been identified.Specifications
| FARSB | |
| Polyclonal | |
| Unconjugated | |
| FARSB | |
| FARSB, FARSLB, FRSB, HSPC173, PheHB, PheRS | |
| Rabbit | |
| Antigen Affinity Chromatography | |
| RUO | |
| 10056, 23874, 301544 | |
| -20°C | |
| Liquid |
| Immunocytochemistry, Immunofluorescence, Immunohistochemistry (Paraffin), Western Blot | |
| 0.13 mg/mL | |
| PBS with 50% glycerol and 0.02% sodium azide; pH 7.3 | |
| Q9NSD9, Q9WUA2 | |
| Farsb | |
| FARSB Fusion Protein Ag9522 | |
| 150 μL | |
| Primary | |
| Human, Mouse, Rat | |
| Antibody | |
| IgG |
Product Content Correction
Your input is important to us. Please complete this form to provide feedback related to the content on this product.
Product Title
Spot an opportunity for improvement?Share a Content Correction